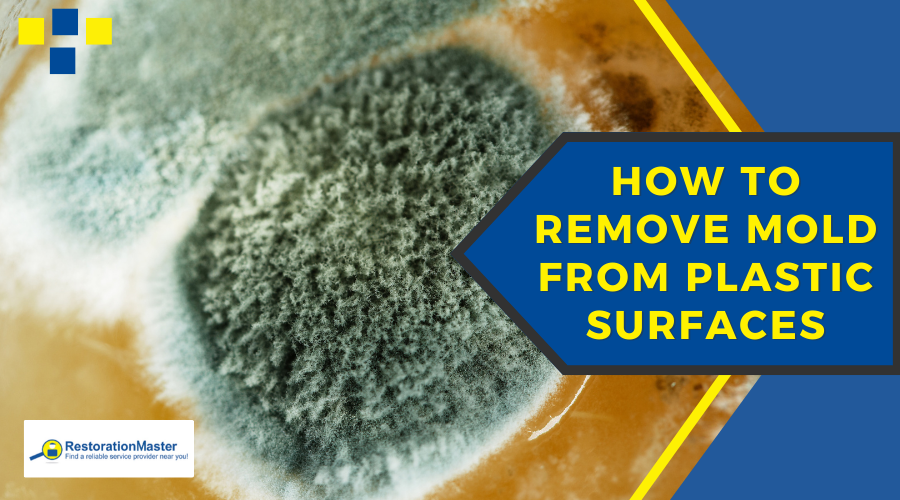
Mold on Plastic Surfaces - RestorationMaster

How to Safely Remove Mold from Plastic Surfaces: Expert Guide
Mold on plastic surfaces might seem unusual, but it happens more often than many homeowners realize. Recently, one of our clients discovered black mold growing on their outdoor storage bins after a particularly rainy season. While plastic itself isn’t mold’s preferred surface, moisture, dust, and organic debris can create the perfect environment for spores to thrive.
In this guide, we’ll explain how mold grows on plastic, walk you through safe and effective cleaning methods, and show when it’s best to discard items to protect your health. We’ll also share practical prevention tips and professional insights from certified mold remediation experts.
Key Takeaways:
- Mold can grow on plastic surfaces under the right conditions, especially if dust, dirt, or additives are present.
- Effective cleaning methods include bleach, undiluted vinegar, or a vinegar-baking soda combination for scrubbing.
- Proper drying after cleaning is essential to prevent regrowth.
- Some items, like scratched food containers or cutting boards, may need to be discarded.
- Professional mold remediation is recommended for large infestations or recurring mold issues.
Why Mold Can Grow on Plastic
Plastic is highly durable; some types take up to 450 years to decompose. Yet mold can thrive when environmental conditions are right:
- Surface debris: Dust, food particles, and other organic material feed mold.
- Moisture and warmth: Spills, condensation, or outdoor exposure create ideal growth conditions.
- Additives in plastic: Components like cellulose, lubricants, or colorants can make plastic more digestible for certain mold species.
Even outdoor plastic furniture, vinyl trim, and garage door seals can develop mold if water intrusion occurs. Proper cleaning and maintenance are key to protecting these items.
Read the EPA’s article: A Brief Guide to Mold, Moisture and Your Home
Step-by-Step: How to Clean Mold from Plastic

Although mold can become embedded in plastic, there are safe and effective methods for removing mold from plastic surfaces, restoring them to a clean and usable state. Here is a step-by-step process to clean mold from plastic:
1. Remove Surface Debris
Before applying any cleaning solution, wipe away dust, dirt, or visible mold. The CDC recommends using gloves and ensuring good ventilation to avoid inhaling spores. A sponge or cloth with antimicrobial soap works well.
2. Prepare a Cleaning Solution
Choose one of the following:
- Bleach solution: 1 cup bleach + 4 liters water. Ideal for stubborn stains but may discolor plastic.
- Undiluted vinegar: Safe for most plastics, effective against odors and mold spores.
- Vinegar + baking soda: Adds scrubbing power for textured surfaces or stubborn black mold.
3. Apply and Soak
- Soak plastic for 15 minutes with bleach or 1 hour with vinegar.
- Use a soft brush or sponge to remove remaining residue.
4. Rinse and Dry Thoroughly
Rinse the plastic completely and dry it quickly. Mold can regrow if moisture remains.
How to Remove Mold from Plastic Items | RestorationMaster Video
When to Discard Moldy Plastic Items
Some items are too difficult to clean safely:
| Item | Condition | Action |
|---|---|---|
| Cutting boards | Deep knife grooves | Discard |
| Plastic food containers | Cracked, scratched, stained | Discard |
| Toys, tools, household goods | Mold embedded in seams or textured areas | Discard |
| Garage door seals/trim | Recurring mold | Clean surface, address water intrusion |
Preventing Mold on Plastic
Once you’ve decided whether to clean or discard a moldy plastic item, the next step is preventing the problem from coming back. Mold thrives in warm, damp environments, so controlling moisture is key.
- Store items in dry, ventilated spaces.
- Wipe plastic down after exposure to moisture.
- For outdoor furniture, clean debris before seasonal storage.
- Monitor recurring mold. Persistent growth may indicate hidden moisture problems.
If you notice recurring mold growth, even after thorough cleaning, it could point to a deeper moisture issue in your home or garage. In those cases, calling a professional mold remediation service can help identify the source, remove mold completely, and protect both your belongings and your health.
When to Call the Professionals for Mold Remediation

Large infestations, recurring mold, or mold affecting multiple surfaces require professional intervention. Certified mold remediation experts:
- Identify and remove hidden mold
- Use specialized cleaning solutions for various surfaces, including plastic
- Ensure mold does not return
If you encounter mold growth on your home, no matter what surfaces are affected, you need to call a mold remediation professional right away. These professionals specialize in removing mold from a variety of surfaces, restoring your property to its original condition with care and precision. They use advanced techniques and state-of-the-art equipment to ensure thorough mold removal and prevent its return. For mold on plastic, they utilize high-quality cleaning solutions to eliminate growth and do their best to salvage the item.
FAQs – Plastic Mold Growth
Can mold really grow on plastic?
Yes, while plastic isn’t mold’s favorite surface, it can grow if moisture, warmth, and dust or organic debris are present. Even outdoor furniture or storage bins can develop mold in the right conditions.
What’s the best cleaner for mold on plastic surfaces?
Bleach works well for stains, and vinegar is great for odor control. For a non-toxic option, vinegar with a little baking soda can be effective. Always rinse and dry thoroughly afterward.
Is it safe to use vinegar on plastic to remove mold?
Absolutely. Undiluted vinegar is safe for most plastics, kills mold spores, and doesn’t release harsh fumes. Just keep in mind it may not remove deep stains as effectively as bleach.
How do I prevent mold from coming back on plastic items?
Keep plastic dry and clean, store it in a well-ventilated area, and wipe down items after they get wet. Regular cleaning helps prevent dust and debris that mold can feed on.
Do mold spores stay on plastic?
Yes, mold spores can cling to plastic surfaces, especially if there’s dust, dirt, or moisture for them to feed on. Even though plastic itself isn’t porous, tiny scratches, textured areas, or surface residue can trap spores and make it easier for mold to grow again. That’s why it’s important to clean thoroughly with a mold-killing solution and dry the item completely to prevent spores from settling back in.
Will rubbing alcohol kill mold on plastic?
Rubbing alcohol (isopropyl alcohol) can kill mold on plastic surfaces, especially when used at 70% concentration or higher. It works best on small, surface-level growth and can help disinfect the area after cleaning. Just remember to scrub away any visible mold first, apply the alcohol directly, let it sit for a few minutes, then rinse and dry the plastic completely to prevent the mold from coming back.








